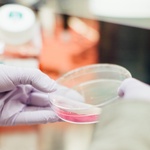

News in January 2024
Page 1 of 1Results 1 to 3 of 3, 09 - 12 January 2024
-
Novel mechanism with potential to boost checkpoint blocking cancer immunotherapies identified
Researchers at the University of Aberdeen working on a partnership study that looks at how the immune system could help improve cancer treatment have found a potential new way to aid and develop better cancer therapies.
-
What becomes of the broken hearted? 'Broken-heart syndrome' patients failed by current treatment

Medication currently given following takotsubo cardiomyopathy diagnosis - also known as broken-heart syndrome is ineffective.
-
PFAS may increase the risk of disease in unborn children, new study suggests

PFAS are chemicals that may cause cancer, diabetes, and other diseases. Research from Örebro University and the University of Aberdeen now suggests that these chemicals affect people as early as the fetal stage of development.
Search News
Browse by month
2026
- Jan
- Feb
- Mar
- Apr
- May
- Jun
- Jul There are no items to show for July 2026
- Aug There are no items to show for August 2026
- Sep There are no items to show for September 2026
- Oct There are no items to show for October 2026
- Nov There are no items to show for November 2026
- Dec There are no items to show for December 2026
2024
2023
- Jan There are no items to show for January 2023
- Feb There are no items to show for February 2023
- Mar There are no items to show for March 2023
- Apr There are no items to show for April 2023
- May There are no items to show for May 2023
- Jun There are no items to show for June 2023
- Jul There are no items to show for July 2023
- Aug There are no items to show for August 2023
- Sep There are no items to show for September 2023
- Oct
- Nov There are no items to show for November 2023
- Dec
2022
- Jan
- Feb There are no items to show for February 2022
- Mar
- Apr There are no items to show for April 2022
- May
- Jun There are no items to show for June 2022
- Jul
- Aug
- Sep There are no items to show for September 2022
- Oct
- Nov There are no items to show for November 2022
- Dec There are no items to show for December 2022
2020
2018
- Jan There are no items to show for January 2018
- Feb There are no items to show for February 2018
- Mar There are no items to show for March 2018
- Apr There are no items to show for April 2018
- May There are no items to show for May 2018
- Jun There are no items to show for June 2018
- Jul
- Aug
- Sep
- Oct
- Nov
- Dec
2017
2016
2012
- Jan There are no items to show for January 2012
- Feb There are no items to show for February 2012
- Mar There are no items to show for March 2012
- Apr There are no items to show for April 2012
- May There are no items to show for May 2012
- Jun There are no items to show for June 2012
- Jul There are no items to show for July 2012
- Aug There are no items to show for August 2012
- Sep
- Oct
- Nov There are no items to show for November 2012
- Dec There are no items to show for December 2012